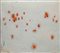

Porro - Via Olona 2, 20123 Milano
Porro - Via Olona 2, 20123 Milano
Asta N. 93 - Opere d’Arte Moderna e Contemporanea, Arti Decorative del ‘900 Sessione Unica - dal lotto 1 al lotto 172
martedì 18 giugno 2019 ore 17:30 (UTC +01:00)
GIULIO TURCATO Mantova 1912 – Roma 1995 SUPERFICIE LUNARE, 1969 CIRCA olio e...
GIULIO TURCATO Mantova 1912 – Roma 1995 SUPERFICIE LUNARE, 1969 CIRCA olio e tecnica mista su gommapiuma, cm 81x91. Firmato in basso a destra: Turcato.Iscritto al verso: Gabriele Stori. Opera archiviata presso l’Archivio Giulio Turcato, Roma, con il numero di repertorio: EZ222914SP05VA